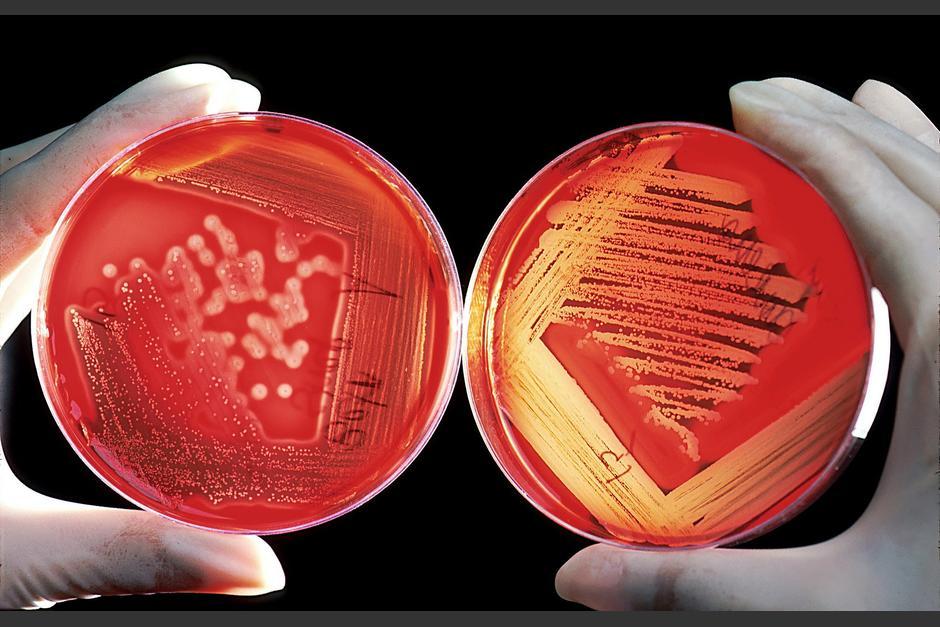
Estados Unidos report&oacute; la propagaci&oacute;n del hongo Candida auris en hospitales y asilos. (Foto: Pixabay)

Es un hongo muy peligroso que ataca a personas con un bajo sistema inmunológico.
OTRAS NOTICIAS: Norovirus, la enfermedad altamente contagiosa que preocupa a la población
Candida Auris, es un hongo que ha demostrado una gran resistencia ante organismos para combatirlo y que pone en riesgo la vida de los pacientes con un sistema inmune bajo.
Pese a que esta infección no es nueva, durante los últimos meses ha causado miedo, pues ha reaparecido en centros hospitalarios.
De acuerdo a información por parte de funcionarios del área de salud de Estados Unidos, han logrado detectar que el "súper hongo" como le han llamado, se propaga en dos hospitales y un asilo de ancianos.
¿Quiénes pueden infectarse con el "súper hongo"?
Especialistas detallaron que esta enfermedad pone en riesgo la salud de pacientes de hospitales con problemas graves de salud.
Asimismo, informaron que se propaga con facilidad por el contacto directo con las personas o con superficies contaminadas.
Las autoridades declararon que un grupo de 101 pacientes de Washington presentó la enfermedad, tres de ellos demostraron que el hongo era resistente en su organismo ante tres fármacos que no lograron combatir la enfermedad.
En Dallas se detectaron a dos pacientes de 22 con ese mismo nivel de resistencia.
Cabe mencionar que de los infectados, tres pacientes murieron, por lo que, Estados Unidos ha activado la alarma, ya que no solamente en una enfermedad mortal sino que se ha vuelto resistente a medicamentos.
“Esta es realmente la primera vez que comenzamos a ver grupos de resistencia” en los que los pacientes parecían contraer infecciones entre sí”, informó la doctora Meghan Lyman.
Los síntomas del "súper hongo"
Las personas que más expuestas están a esta afección son aquellas que sufren algún tipo de enfermedad como: cáncer, diabetes, problemas renales, sistema inmunológico débil y hasta aquellas personas que fuman o se encuentran en recuperación de una cirugía.
Además, este hongo provoca enfermedades invasivas que llegan a afectar severamente el corazón, cerebro y la sangre de las personas, estos son algunos de los síntomas más comunes.
- Fiebre
- Dolor
- Fatiga
- Mareos
- Vómitos
- Aumento de la frecuencia cardíaca